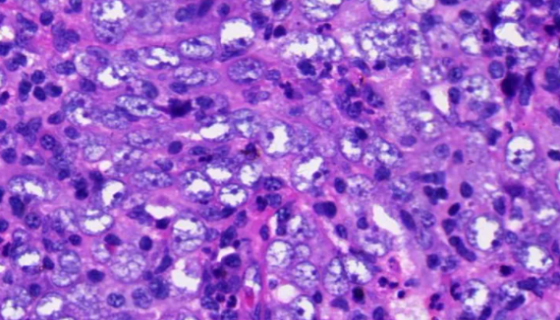
CNE1人鼻咽癌细胞接收后的操作流程与注意事项！

人肾实质细胞的背景与使用方法及应用!
人肾实质细胞分离自肾组织;肾脏是机体的重要器官,它的基本功能...

MCMEC小鼠心脏微血管内皮细胞的培养步骤与处理方法!
小鼠心脏微血管内皮细胞,微血管内皮细胞呈单层覆盖于微血管表面...

牙龈卟啉单胞菌 ATCC BAA-3083 百欧博伟生物
牙龈卟啉单胞菌是一种非酵解糖的革兰氏阴性厌氧球杆菌,是研究广...

布氏乳杆菌的培养条件与注意事项及打管说明!
布氏乳杆菌是Lactobacillus属的微生物,原产地为中...

金黄色葡萄球菌金黄亚种冻干管打管说明书!
金黄色葡萄球菌金黄亚种是Staphylococcus属的微生...

ATCC 700264 淡水趋磁螺菌 百欧博伟生物
趋磁螺细菌是Magnetospirillum属的微生物,原产...
CNE1人鼻咽癌细胞接收后的操作流程与注意事项!
人鼻咽癌细胞,仅用于科学研究或者工业应用等非医疗目的不可用于...

表皮葡萄球菌的细胞形态和生物化学及鉴定方法!
表皮葡萄球菌是一种革兰氏阳性菌,属于葡萄球菌属的40多种物种...

MIHA人正常肝细胞的处理方法与培养步骤!
人正常肝细胞,仅用于科研工作,未经许可不得用于其他目的,使用...